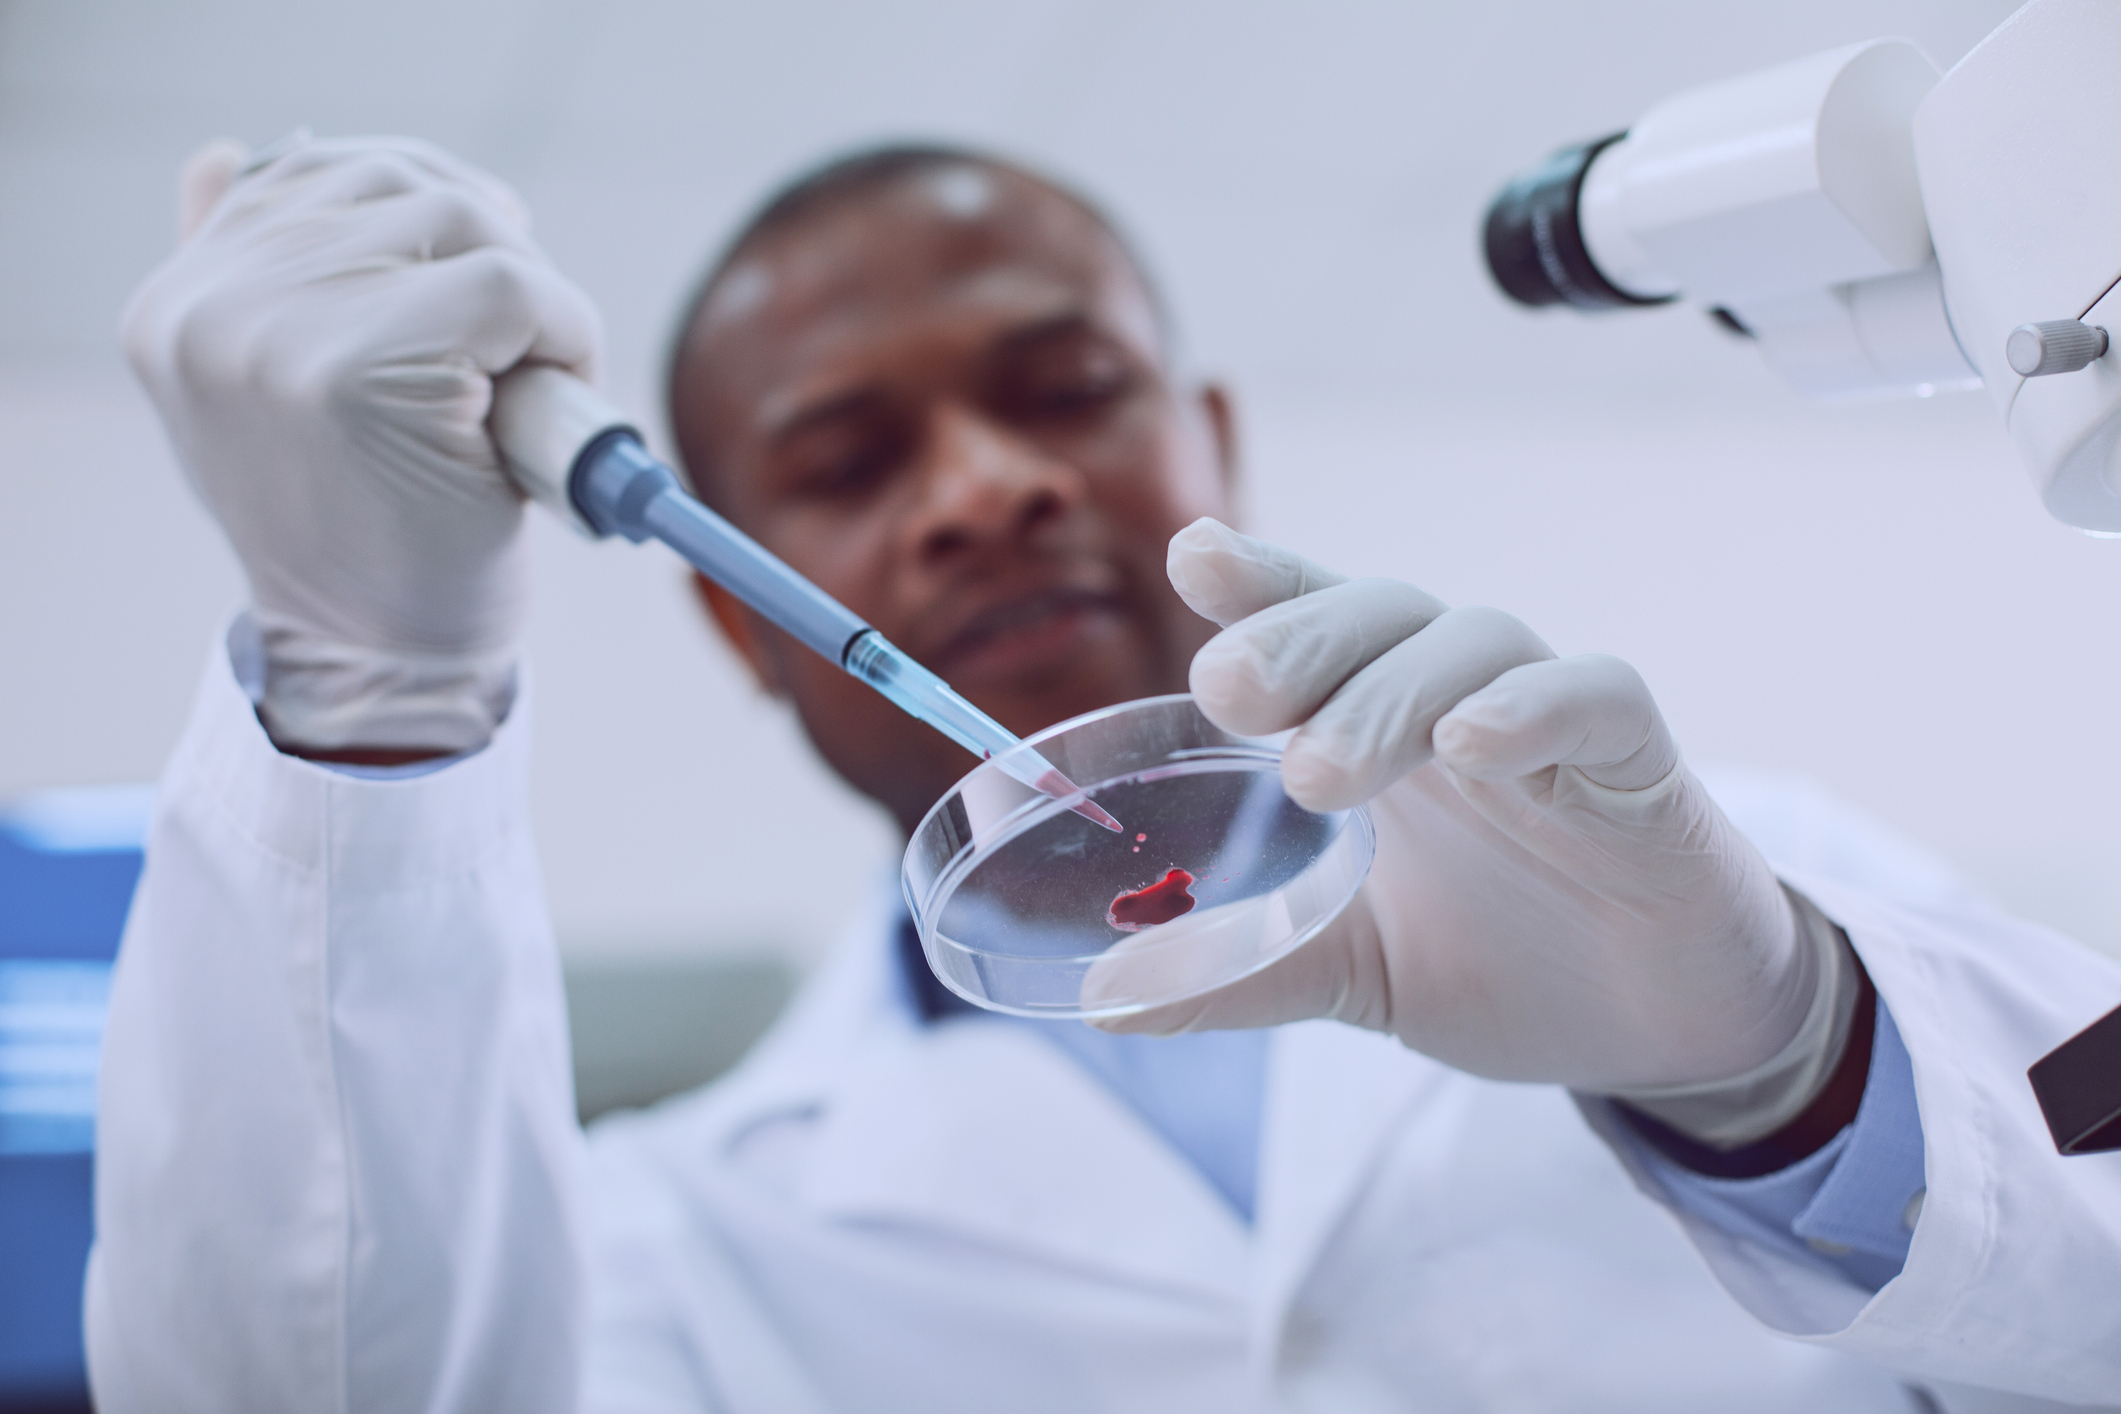

Guardant Health (GH +1.94%), a cancer diagnostics company focused on liquid biopsies, reported fourth-quarter and full-year results Tuesday.
Revenue grew 64% during the quarter as demand for its Guardant360 and GuardantOMNI product lines continues to take off. The picture wasn't as rosy on the bottom line, but that is a direct result of management investing heavily in its commercial team, as well as research and development programs.
Guardant Health Q4: The raw numbers
Metric |
Q4 2018 |
Q4 2017 |
Year-Over-Year Change |
---|---|---|---|
Sales |
$32.9 million |
$20 million |
64% |
Net income |
($25.1 million) |
($15.1 million) |
N/A |
EPS |
($0.30) |
($1.27) |
N/A |
Data source: Guardant Health. EPS = earnings per share.
What happened with Guardant Health this quarter?
- Precision oncology testing revenue, which is earned from Guardant360 and GuardantOMNI liquid biopsy product lines, grew 98% to $28.1 million. The huge gain was driven by a combination of double-digit volume growth and an increase in the revenue received per test.
- Development services revenue, which is earned from its partnerships with biopharmaceutical companies and is lumpy by nature, declined 19% to $4.8 million. This number fluctuates from quarter to quarter since it depends on the start and end times of certain drug discovery and development programs.
- The sales leverage helped gross margin expand by 330 basis points to 57.6%.
- Operating expenses ballooned by 75% to $46.3 million. This rate of increase outpaced revenue growth.
- Net loss expanded by 67% to $25.1 million, or $0.30 per share.
- Cash balance at year-end was $496.5 million.
- Guardant360 insurance coverage for non-small cell lung cancer testing grew from 77 million lives at the end of the third quarter of 2018 to 115 million lives at year end.
- The company signed a multiyear agreement with AstraZeneca during the quarter to use its liquid biopsies to further the development of the drugmaker's oncology portfolio.
Check out the latest earnings call transcript for Guardant Health.
Here's how the company's numbers shook out for full-year 2018:
- Revenue grew 82% to $90.6 million, beating the high end of management's guidance range of $82 million to $84 million.
- Testing volume for clinical customers and biopharmaceutical customers increased by 15% and 65%, respectively, to 29,592 and 10,370.
- Gross margin soared from 36.6% in 2017 to 52.3% in 2018.
- Operating expenses expanded 48% to $140.4 million.
- Net loss declined by 4% to $85.1 million, or $2.80 per share.
Guardant also recently announced that its Nile study showed the Guardant360 liquid biopsy product was able to detect a similar number of targetable biomarkers in patients with lung cancer, when compared to current standard-of-care tissue testing. This data supports the idea of using Guardant360 liquid biopsies prior to initiating tissue testing.
What management had to say
CEO Helmy Eltoukhy succinctly summarized the progress made during the year:
During 2018, we made important headway on key initiatives and are continuing to see strong adoption of our liquid biopsy platform, which has driven increased revenue of more than 80 percent over the prior year. We believe the recent NILE readout is an important catalyst supporting a blood-first paradigm for first-line use of Guardant360 testing for treatment selection ahead of tissue testing, offering lung cancer patients improved care with a faster time to treatment.
Eltoukhy commented on the company's decision to invest heavily in the development of its LUNAR clinical studies. These trials promise to open up Guardant's liquid biopsies to millions of cancer survivors and people who could benefit from regular cancer screenings.
He said, "In addition, we are encouraged by the progress we are making with our LUNAR program and look forward to presenting pilot LUNAR data at the AACR conference next month. As a result of these developments, we are ramping up investment to accelerate our research and development efforts toward earlier cancer detection."
Looking forward
Management expects that Guardant's rapid pace of growth will continue into 2019. The company is currently forecasting that full-year revenue will land between $130 million and $135 million, which would represent growth between 43% and 49%.
The picture won't be as pretty on the bottom line, with net loss expected to increase in a range of $126 million to $129 million. That's a big jump from the $85.1 million net loss in 2018.
The good news is that Guardant ended the year with nearly $500 million in cash, so it should have no problems funding the expected loss without needing to tap shareholders for cash.